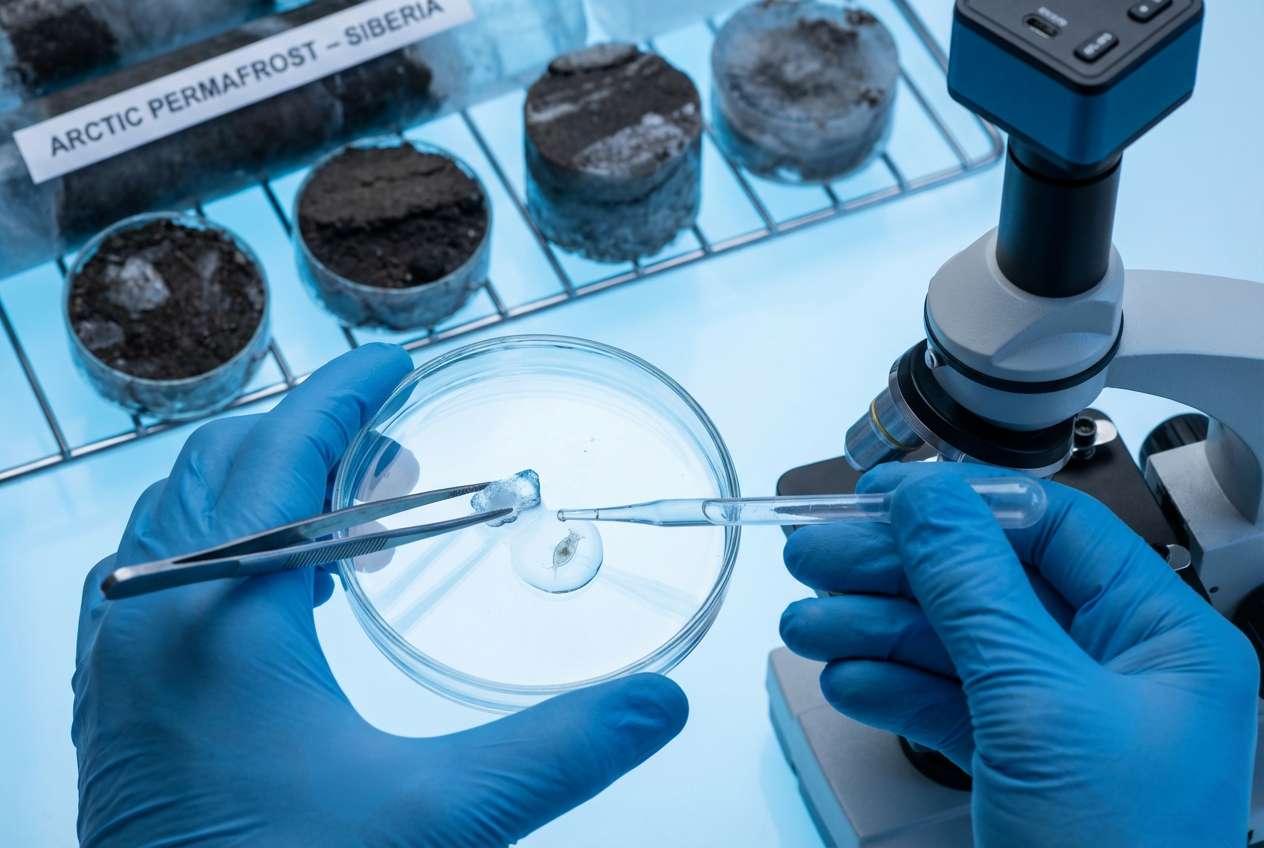
Scientists Revive a 24,000-Year-Old Animal from Siberian Ice

U.S. News
Scientists Revive a 24,000-Year-Old Animal from Siberian Ice
Clear Facts
- Researchers successfully revived a microscopic multicellular rotifer that remained frozen in Siberian permafrost for 24,000 years.
- The organism survived in a state of cryptobiosis, which nearly stops metabolic activity to endure extreme conditions such as freezing and dehydration.
- Upon thawing, the ancient creature resumed normal biological functions and began reproducing asexually, proving its cellular integrity remained intact.
Scientists identified the tiny animal within the ice-rich Yedoma formation dating back to the Late Pleistocene. This discovery marks the hardest proof available that multicellular life can withstand tens of thousands of years in suspended animation.
While single-celled organisms are frequently revived from ice, the survival of complex animals presents significant scientific interest. Rotifers possess specialized systems including digestive tracts, making their durability through millennia particularly notable.
“Our report is the hardest proof as of today that multicellular animals could withstand tens of thousands of years in cryptobiosis, the state of almost completely arrested metabolism,” lead researcher Stas Malavin said.
The study suggests these findings could provide valuable insights for biotechnology and understanding how cells resist damage from ice crystals over time. However, experts note that this process does not translate to larger mammals due to their biological complexity.
The research also highlights that as permafrost thaws, other long-dormant microbes could be released into the modern environment. This potential release prompts new questions regarding future environmental and health considerations outside of laboratory settings.
Let us know what you think, please share your thoughts in the comments below.